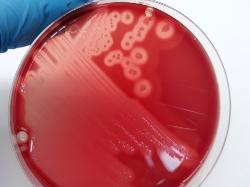

| Clostridium perfringens |
| Clostridium perfringens colonies producing double hemolysis on sheep blood agar |
| C. perfringens cells. Gram staining. |
| C. perfringens curd formed and disrupted by intense gas production (left) |
Taxonomy
Morphology
Cultural characteristics
Biochemical characters
Ecology
Pathogenicity
References
Phylum Bacillota (Firmicutes), Class Clostridia, Order Eubacteriales, Family Clostridiaceae, Genus Clostridium, Cluster I
(Clostridium sensu stricto), Clostridium perfringens (Veillon and Zuber 1898) Hauduroy, Ehringer, Urbain, Guillot and Magrou 1937.
Clostridium perfringens has been divided into five types (A, B, C, D, and E) on the basis of production of major lethal toxins. Type A
produces alpha toxin; type B produces alpha, beta, and epsilon toxins; type C produces alpha and beta toxins; type D alpha and
epsilon toxins; type E produces alpha and iota toxins.
Historical synonyms: Bacillus perfringens Veillon and Zuber 1898, Bacterium welchii Migula 1900.
(Clostridium sensu stricto), Clostridium perfringens (Veillon and Zuber 1898) Hauduroy, Ehringer, Urbain, Guillot and Magrou 1937.
Clostridium perfringens has been divided into five types (A, B, C, D, and E) on the basis of production of major lethal toxins. Type A
produces alpha toxin; type B produces alpha, beta, and epsilon toxins; type C produces alpha and beta toxins; type D alpha and
epsilon toxins; type E produces alpha and iota toxins.
Historical synonyms: Bacillus perfringens Veillon and Zuber 1898, Bacterium welchii Migula 1900.
Gram-positive straight rods, 0.6-2.4 x 1.3-19.0 µm, occuring singly or in pairs in PYG
(peptone yeast extract containing glucose) broth cultures. Nonmotile. Spores are oval,
large, central/subterminal, swelling the cell; spores are rarely seen in vivo or in the
usual in vitro conditions. Approximately three-quarters of strains possess a capsule
that is composed largely of polysaccharides.
(peptone yeast extract containing glucose) broth cultures. Nonmotile. Spores are oval,
large, central/subterminal, swelling the cell; spores are rarely seen in vivo or in the
usual in vitro conditions. Approximately three-quarters of strains possess a capsule
that is composed largely of polysaccharides.
Surface colonies on blood agar plates are 2-5 mm in diameter, dome-shaped,
translucent with a glossy surface, gray to grayish yellow. Colonies in agar are
usually lenticular. The type of hemolysis present depends on both the species of
blood andthe type of Clostridium perfringens being examined; the three types of
hemolysins that may be produced in varying quantities are designated alpha, delta,
and theta.
On rabbit, sheep, cow, horse, or human blood, most strains produce a narrow zone
of complete hemolysis due to the theta toxin and a surrounding zone of incomplete
hemolysis due to the alpha toxin. Some type B and C strains may produce a very
wide zone of haemolysis on sheep or cow blood due to delta toxin.
Moderate growth in nutrient broth; rapid growth in broth with fermentable
carbohydrate. Cultures in PYG broth are turbid with a smooth sediment and have a
pH of 4.8–5.6 after 1 week incubation. Abundant gas is produced in PYG deep agar
cultures.
Growth is inhibited by 6.5% NaCl but not by 20% bile. Grows at: 20-50 ºC, optimum
at 37-45 ºC. Optimum growth at pH 5.5-8.0.
translucent with a glossy surface, gray to grayish yellow. Colonies in agar are
usually lenticular. The type of hemolysis present depends on both the species of
blood andthe type of Clostridium perfringens being examined; the three types of
hemolysins that may be produced in varying quantities are designated alpha, delta,
and theta.
On rabbit, sheep, cow, horse, or human blood, most strains produce a narrow zone
of complete hemolysis due to the theta toxin and a surrounding zone of incomplete
hemolysis due to the alpha toxin. Some type B and C strains may produce a very
wide zone of haemolysis on sheep or cow blood due to delta toxin.
Moderate growth in nutrient broth; rapid growth in broth with fermentable
carbohydrate. Cultures in PYG broth are turbid with a smooth sediment and have a
pH of 4.8–5.6 after 1 week incubation. Abundant gas is produced in PYG deep agar
cultures.
Growth is inhibited by 6.5% NaCl but not by 20% bile. Grows at: 20-50 ºC, optimum
at 37-45 ºC. Optimum growth at pH 5.5-8.0.
Isolated from soil, marine sediments, wounds, feces, clothing, raw milk, cheese,
semipreserved meat products, intestinal contents of animals. This species is more
widely spread in nature than any other pathogenic microorganism. Humans and
animals frequently carry Clostridium perfringens as part of the normal endogenous
flora.
Most strains are susceptible to bacteriocins produced by enterococci.
Some soil isolates of Clostridium perfringens produce inhibitors that are active
against some or all of Clostridium botulinum types A, B, E, and F. Clostridium
perfringens also produces bacteriocins that are active against
other strains of Clostridium perfringens. Bacteriocin production and resistance to
that
bacteriocin is related to the presence of a plasmid.
Most beta-lactams, particularly penicillin G, are quite active against C. perfringens.
Aminoglycosides are inactive against C. perfringens. Plasmid-mediated resistance
of C. perfringens to clindamycin-erythromycin, to tetracycline-chloramphenicol, and to
tetracycline alone has been described.
semipreserved meat products, intestinal contents of animals. This species is more
widely spread in nature than any other pathogenic microorganism. Humans and
animals frequently carry Clostridium perfringens as part of the normal endogenous
flora.
Most strains are susceptible to bacteriocins produced by enterococci.
Some soil isolates of Clostridium perfringens produce inhibitors that are active
against some or all of Clostridium botulinum types A, B, E, and F. Clostridium
perfringens also produces bacteriocins that are active against
other strains of Clostridium perfringens. Bacteriocin production and resistance to
that
bacteriocin is related to the presence of a plasmid.
Most beta-lactams, particularly penicillin G, are quite active against C. perfringens.
Aminoglycosides are inactive against C. perfringens. Plasmid-mediated resistance
of C. perfringens to clindamycin-erythromycin, to tetracycline-chloramphenicol, and to
tetracycline alone has been described.
Pathogenic for man and animals. Pathogenic for laboratory animals; type strain's
culture supernatants are toxic to mice.
Produces soluble substances that cause a variety of toxic effects in in vitro and in vivo
conditions. Can produce up to 16 toxins in various combinations, including 4 major
toxins (alpha, beta, epsilon and iota) and other lethal toxins (perfringolysin O,
enterotoxin and beta2 toxin). Alpha toxin is essential in the production of gas
gangrene of humans and several animal species. Beta toxin is responsible for
necrotizing enteritis and enterotoxemia in neonatal individuals of sheep, goat, cattle.
Epsilon toxin is responsible for enterotoxemia in sheep and goats. Enterotoxin is
responsible for gastrointestinal disease in humans and dogs, horses, pigs, goat. Iota
toxin produce enteritis at sheep and cattle and enterotoxemia in rabbits. Perfringolysin
O has possible synergism with alpha and epsilon toxins. Beta2 toxin produce
neonatal diarrhea in pigs.
Clostridium perfringens is the species of Clostridium most commonly isolated from
infections in humans; such infections are often polymicrobial. It is most commonly
recovered from infections derived from the colonic flora (e.g., peritonitis,
intra-abdominal abscess, and soft tissue infections below the waist).
culture supernatants are toxic to mice.
Produces soluble substances that cause a variety of toxic effects in in vitro and in vivo
conditions. Can produce up to 16 toxins in various combinations, including 4 major
toxins (alpha, beta, epsilon and iota) and other lethal toxins (perfringolysin O,
enterotoxin and beta2 toxin). Alpha toxin is essential in the production of gas
gangrene of humans and several animal species. Beta toxin is responsible for
necrotizing enteritis and enterotoxemia in neonatal individuals of sheep, goat, cattle.
Epsilon toxin is responsible for enterotoxemia in sheep and goats. Enterotoxin is
responsible for gastrointestinal disease in humans and dogs, horses, pigs, goat. Iota
toxin produce enteritis at sheep and cattle and enterotoxemia in rabbits. Perfringolysin
O has possible synergism with alpha and epsilon toxins. Beta2 toxin produce
neonatal diarrhea in pigs.
Clostridium perfringens is the species of Clostridium most commonly isolated from
infections in humans; such infections are often polymicrobial. It is most commonly
recovered from infections derived from the colonic flora (e.g., peritonitis,
intra-abdominal abscess, and soft tissue infections below the waist).
- N.A. Logan and P. De Vos, 2009. Genus I. Clostridium Prazmowski 1880. In: (Eds.) P.D. Vos, G. Garrity, D. Jones, N.R. Krieg, W.
Ludwig, F.A. Rainey, K.-H. Schleifer, W.B. Whitman. Bergey’s Manual of Systematic Bacteriology, Volume 3: The Firmicutes,
Springer, 738-828. - Smith L.D.S. and Hobbs G., 1975. Genus III. Clostridium Prazmowski 1880. In: (Eds.) Buchanan R.E. and Gibbons N.E., Bergey’s
Manual of Determinative Bacteriology, Eighth Edition, The Williams & Wilkins Company, Baltimore, 551-572. - Uzal F.A., Vidal J.E., McClane B.A. and Gurjar A.A., 2010. Clostridium perfringens toxins involved in mammalian veterinary
diseases. The Open Toxinology Journal, 3, 24-42. - Secasiu V., 2001. Boli produse de germeni din genul Clostridium. In: Boli infectioase ale animalelor, Moga Manzat R., Ed. Brumar,
Timisoara, 481-612.
Products in PYG broth are butyric, acetic, and lactic acids. H2 is produced very
abundantly. Milk reaction: positive (stormy). Meat digestion is variable.
Positive results for hydrolysis of gelatin, H2 production, lecithinase, neutral red
reduction, substrate utilized and/or acid produced from: fructose, galactose (weak),
glucose, lactose, maltose, mannose & sucrose.
Negative results for indole production, lipase, substrate utilized and/or acid
produced from: arabinose, mannitol, melezitose, rhamnose, salicin & xylose.
Variable results for DN-ase, H2S production, nitrate reduction, casein hydrolysis,
esculin hydrolysis, hippurate hydrolysis, starch hydrolysis, resazurin reduction,
urease, Voges-Proskauer reaction, substrate utilized and/or acid produced from:
amygdalin (weak), cellobiose, dulcitol, glycogen, glycerol (weak), inositol, inulin
(weak), melibiose (weak), raffinose, ribose, sorbitol, sorbose (weak), starch &
trehalose.
abundantly. Milk reaction: positive (stormy). Meat digestion is variable.
Positive results for hydrolysis of gelatin, H2 production, lecithinase, neutral red
reduction, substrate utilized and/or acid produced from: fructose, galactose (weak),
glucose, lactose, maltose, mannose & sucrose.
Negative results for indole production, lipase, substrate utilized and/or acid
produced from: arabinose, mannitol, melezitose, rhamnose, salicin & xylose.
Variable results for DN-ase, H2S production, nitrate reduction, casein hydrolysis,
esculin hydrolysis, hippurate hydrolysis, starch hydrolysis, resazurin reduction,
urease, Voges-Proskauer reaction, substrate utilized and/or acid produced from:
amygdalin (weak), cellobiose, dulcitol, glycogen, glycerol (weak), inositol, inulin
(weak), melibiose (weak), raffinose, ribose, sorbitol, sorbose (weak), starch &
trehalose.
(c) Costin Stoica

| Antibiogram |
| Encyclopedia |
| Culture media |
| Biochemical tests |
| Stainings |
| Images |
| Movies |
| Articles |
| Identification |
| Software |
| R E G N U M PROKARYOTAE |



| Back |